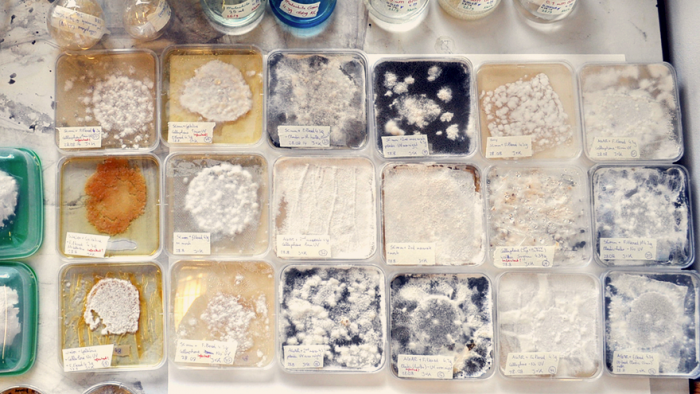

It is estimated that the world produces over 300 million tonnes of plastic each year. Manufactured for its durability and moldable nature, plastic has become the favourite vehicle to contain products cheaply and make them last a long time.
But this durability poses a problem for the natural world, as plastic lingers in the environment long after it has been discarded. Plastic toxifies oceans, soil and often fatally ends up in the stomachs of critters. The global desire for more organically-produced, biodegradable goods has helped this pollution problem to some degree and now scientists are considering ways to tackle the question at its core – how can plastic waste be degraded naturally?
One group of scientists approached the breaking down of plastic on a molecular level. Japanese researchers have discovered a species of bacteria that consumes plastic fibres. It is called Ideonella sakaiensis 201-F6, a microscopic bug that seems to eat PET plastic (often used to manufacture bottles) and use it as an energy source. Scientists of Keio University in Japan identified the novel bacterium which could completely disintegrate a thin layer of plastic when kept at a temperature of 30 degrees Celsius.
Another project is called Fungi Mutarium, a novel food experiment led by Austrian product designer Katherina Unger in collaboration with scientists from Utrecht University, Netherlands. It is a project with eco-friendliness through food science at its heart.
This video, produced by LIVIN Studio, illustrates Unger’s experiment which involves injecting a hollowed ball of agar (which is a gelatin extracted from seaweed acting as a foundation) with UV-treated sheets of plastic along with tiny specimens of the mushroom. The fungus breaks down the plastic and eventually only the ball of agar remains, sporting a layer of furry sprouts. While Fungi Mutarium is still in early prototype stages, it does show how the boundaries of non-biodegradable material can be crossed – with delicious results.
A similar research project simply involved setting waxworms loose on one of their favourite snack foods – which happens to be plastic. The waxworm got its name from its apetite for the wax comb inside beehives. After cleaning up an infestation of them in a beehive she keeps at home, scientist Federica Bertocchini was astonished to find the worms happily chomping their way out of a plastic bag.
Bertocchini, a researcher of the Institute of Biomedicine and Biotechnology of Cantabria in Spain, documented a number of experiments showing how a hundred of these caterpillars would shred a shopping bag in a matter of hours. Weirdly, the only residue of the waxworms feasting on polyethylene is anti-freeze, confirming the degradation of the plastic.